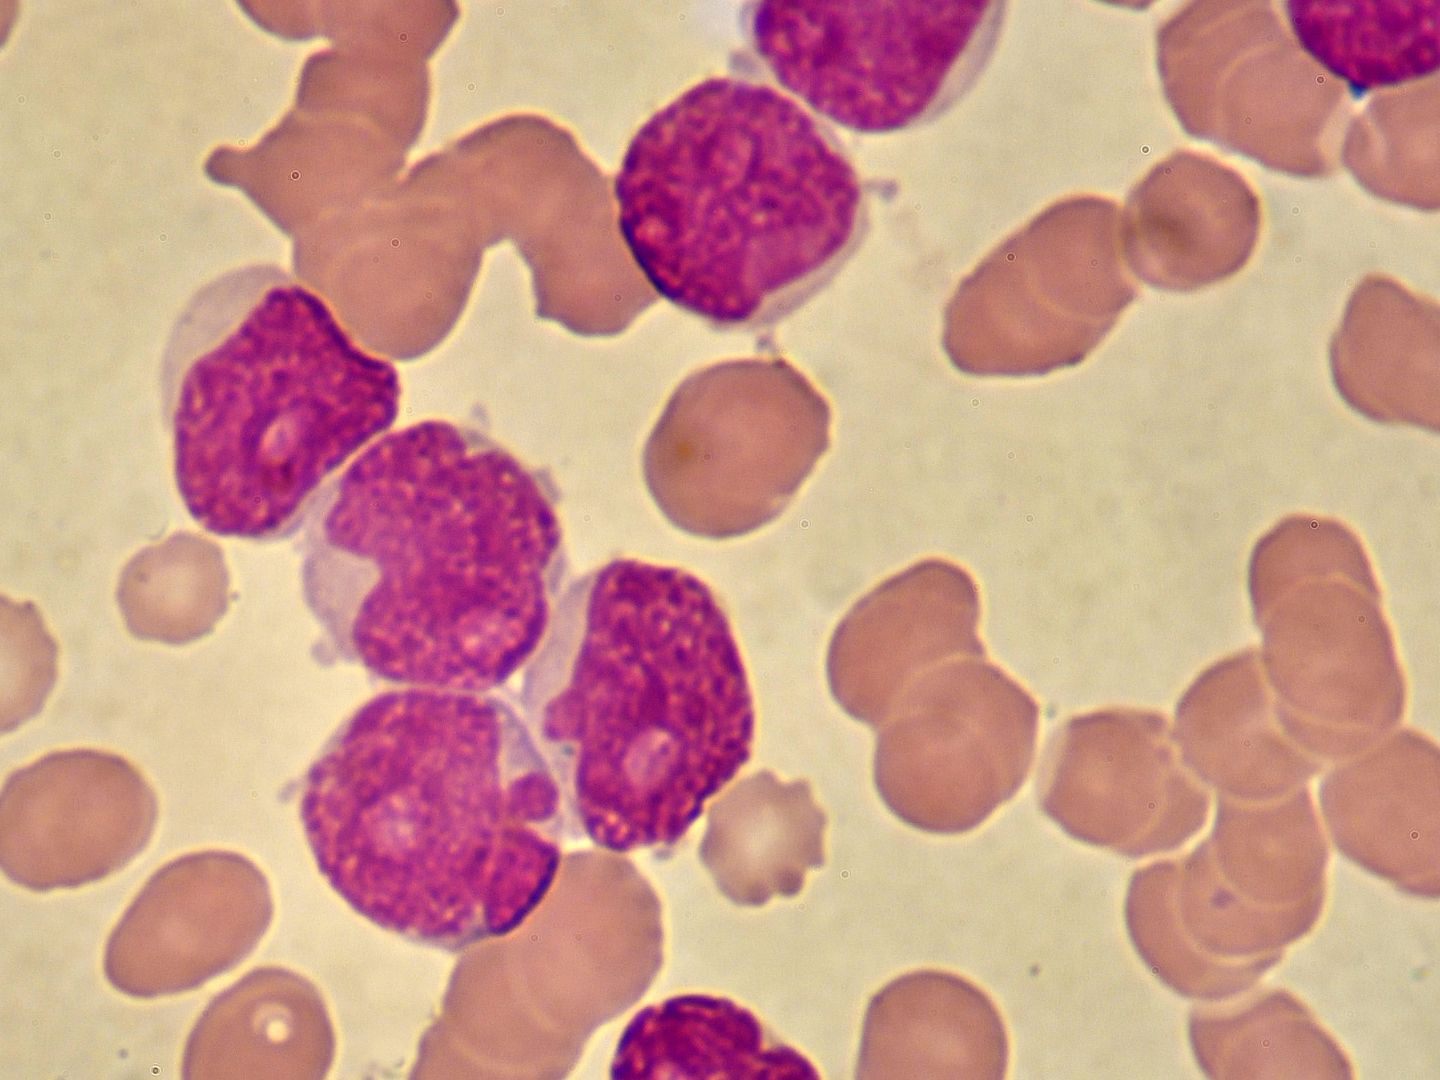

Neue Behandlungsmethode bei chronisch lymphatischer Leukämie besser und verträglicher
Die MedUni am AKH Wien sprach am Mittwoch von einem bedeutenden Fortschritt und dem "Potenzial, den Therapiestandard für CLL-Patientinnen und -patienten zu revolutionieren". Die Studie zu der Kombination mit den Medikamenten Venetoclax und Obinutuzumab wurde unter Mitwirkung der MedUni durchgeführt.
Lang anhaltende Krankheitsfreiheit nach neuer CLL-Behandlungsweise
Die zeitlich begrenzte und zielgerichtete Therapie sei bei Patientinnen und Patienten ohne Begleiterkrankungen effektiver als die Chemoimmuntherapie gewesen, hieß es in einer Aussendung. In der Studie unter der Koordination von Philipp Staber von der Universitätsklinik für Innere Medizin I der MedUni Wien waren 926 CLL-Betroffene - auch zahlreiche aus Österreich - involviert.
"Die Therapie führt bei 86,5 Prozent der Patientinnen und Patienten zu einer so starken Verringerung der CLL Zellen, dass diese im Blut der Patienten nicht mehr nachgewiesen werden können (MRD Negativität), und ermöglicht eine lang anhaltende Krankheitsfreiheit. Darüber hinaus treten im Vergleich zur Chemoimmuntherapie weniger Nebenwirkungen auf", betonte Staber.
Basierend auf den Ergebnissen empfehlen die Forschenden die Kombinationstherapie aus Obinutuzumab und Venetoclax nun als neuen Standard für fitte CLL-Patienten, unabhängig von ihrem Alter. Das bietet laut Staber Hoffnung für Betroffene und könne die Lebensqualität der Patienten verbessern und ihnen eine längere Krankheitsfreiheit und Therapiefreiheit ermöglichen. Die Studie wurde im renommierten Journal "The New England Journal of Medicine" veröffentlicht.
(APA/Red.)
Du hast einen Hinweis für uns? Oder einen Insider-Tipp, was bei dir in der Gegend gerade passiert? Dann melde dich bei uns, damit wir darüber berichten können.
Wir gehen allen Hinweisen nach, die wir erhalten. Und damit wir schon einen Vorgeschmack und einen guten Überblick bekommen, freuen wir uns über Fotos, Videos oder Texte. Einfach das Formular unten ausfüllen und schon landet dein Tipp bei uns in der Redaktion.
Alternativ kannst du uns direkt über WhatsApp kontaktieren: Zum WhatsApp Chat
Herzlichen Dank für deine Zusendung.


